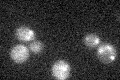
YMR264W

View description
Endoplasmic reticulum membrane protein that recruits the ubiquitin-conjugating enzyme Ubc7p to the ER where it functions in protein degradation; contains a CUE domain that binds ubiquitin to facilitate intramolecular monoubiquitination
Localization:
Intensity:
Fold change:
Significance:
-
C’ GFP library in SD

below threshold13.76 -
N' NOP1pr-GFP in SD

cell periphery,punctate,nucleus75.1406 -
N' TEF2pr-mCherry in SD

ER,punctate31.8174 -
N' NATIVEpr-GFP in SD

below threshold20.0994 -
N' TEF2pr-VC and Cyto-VN in SD

#N/A0 -
C’ GFP library in SD+DTT

cytosol15.191.1No -
C’ GFP library in SD+H2O2
cytosol13.811No -
C’ GFP library in Starvation Media

cytosol16.51.19No -
C’ GFP library on the background of Pup2-DaMP

below threshold -
C’ GFP library on the background of CCT mutant

below threshold14.57421.0588No
